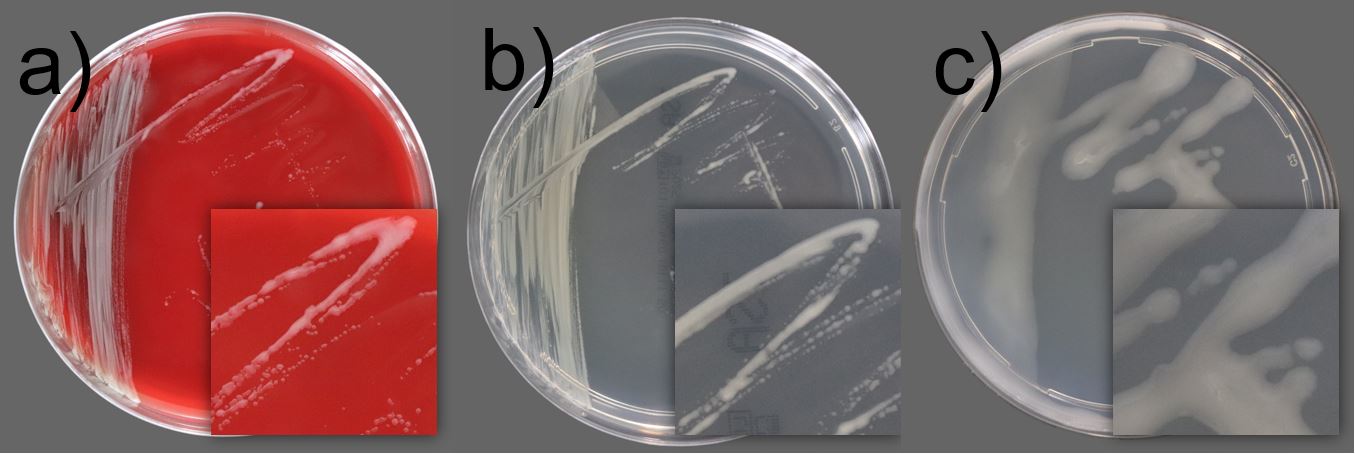

Blog
Filtergängige Bakterien - Risiko bei der aseptischen Herstellung
Unter bestimmten Bedingungen können selbst intakte und validierte Sterilfilter mikrobiologische Durchgänge zulassen – ein Phänomen, das in der aseptischen Herstellung häufig unterschätzt wird. Diese filtergängigen Bakterien stellen eine besondere Herausforderung für die Qualitätssicherung dar, da sie die verbreitete Annahme infrage stellen, der Sterilfilter sei stets die letzte und zuverlässigste Sicherheitsbarriere im Prozess.
Die Biologin Julia Homer (Labor LS) und Dr. Frank Mertens, Laboratory Consultant, beleuchten in ihrem Fachbeitrag die biologischen und physikalischen Mechanismen, die hinter diesem Phänomen stehen. Sie erklären, wie es unter bestimmten Prozessbedingungen – etwa bei bestimmter Temperatur, Differenzdruck oder Durchsatzmenge – zu mikrobiologischen Durchgängen kommen kann.
Anhand ausgewählter Beispiele stellen sie relevante Mikroorganismen vor, die trotz validierter Filtration passieren können. Dabei zeigen sie Beispiele auf, wie mit mikrobiologischer Belastung umgegangen werden sollte und wie das Risiko minimiert werden kann. Dazu gehören unter anderem die gezielte Auswahl geeigneter Filter, die regelmäßige Überprüfung der Prozessbedingungen sowie ein tiefes mikrobiologisches Verständnis in der Routineüberwachung.
Der Beitrag wurde in der Fachzeitschrift cleanroom & processes des ECV Editio Cantor Verlags (Ausgabe 4/2025) veröffentlicht. Ziel der Publikation ist es, das Bewusstsein für mikrobiologische Risiken über den menschlichen Faktor hinaus zu schärfen und das Verständnis für eine ganzheitliche Kontaminationskontrolle in der aseptischen Produktion zu vertiefen.
Auf der folgenden Seite können Sie die Publikation als PDF bestellen:
Publikation Filtergängige Bakterien | Labor LS SE & Co. KG
Es freut uns, wenn Sie diesen Blogbeitrag kommentieren. Kommentar erfassen 21 Gefällt mir 101















































































































































